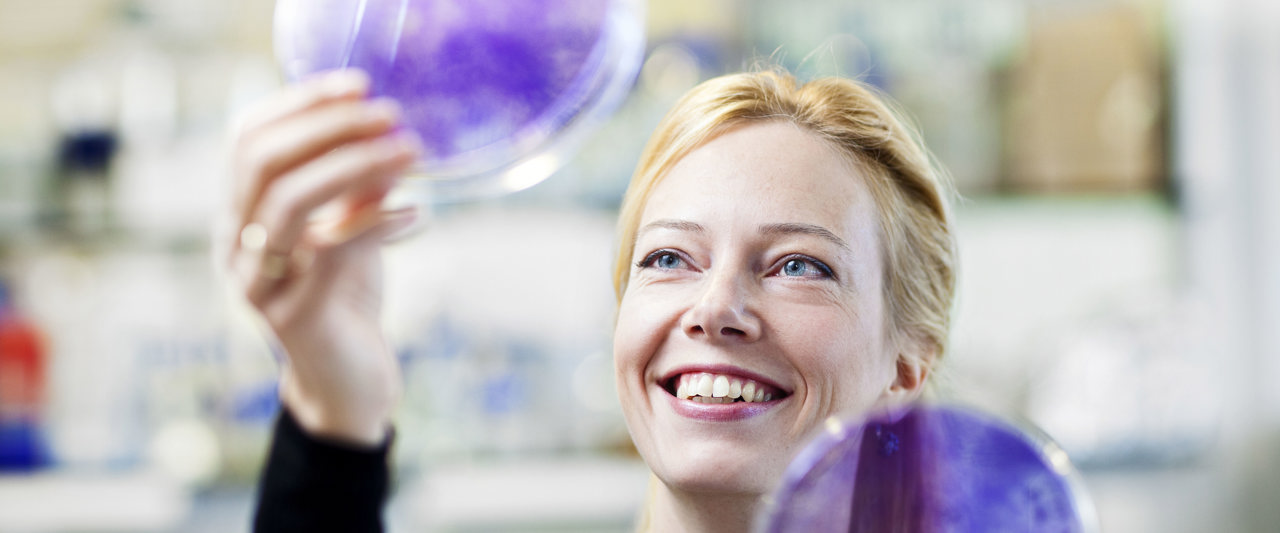
Jacqueline Jacobs onderzoek NKI

Elk jaar identificeert Clarivate Analytics, een Amerikaans bedrijf dat diensten aanbiedt voor wetenschappelijk onderzoek, 's werelds meest invloedrijke onderzoekers: het selecte groepje dat de afgelopen tien jaar het vaakst is geciteerd door vakgenoten. In 2022 hebben meer dan 7.000 wetenschappers, ongeveer 0,1% van alle onderzoekers ter wereld, deze exclusieve onderscheiding verdiend.
De onderzoekers Jos Beijnen, Christian Blank, John Haanen, Egbert Smit en Ton Schumacher behoren tot de top 1% van de meest geciteerde onderzoekers in de afgelopen 10 jaar. John Haanen werd erkend omdat hij vaak is geciteerd op het gebied van de klinische geneeskunde, de anderen werden erkend omdat zij op meerdere gebieden werden geciteerd.
Inclusie in de lijst gebeurt aan de hand van het aantal citaties. Dit zegt niet noodzakelijk iets over de kwaliteit van het werk, maar geeft wel aan dat het werk door andere wetenschappers wordt gebruikt.
Over de lijst van geciteerde onderzoekers
Dit jaar zijn 7.225 onderzoekers uit 69 verschillende landen en regio's erkend op de Highly Cited lijst, waarvan in totaal 210 onderzoekers van Nederlandse universiteiten en onderzoekscentra. De top drie van landen met het grootste aantal geciteerde onderzoekers bestaat uit de Verenigde Staten, China en het Verenigd Koninkrijk.